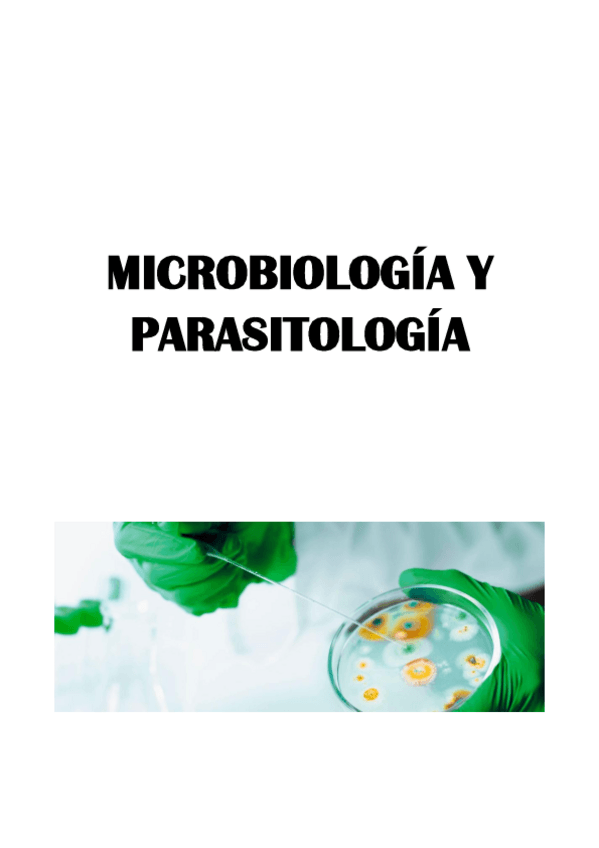

@nutri_80
16 Publicaciones
532 Interacciones
0 Seguidores
0 Siguiendo
Lista de publicaciones de nutri_80
He publicado nuevos apuntes de 3º Dietética Hospitalaria: dietetica-hospitalaria-2.pdf
He publicado nuevos apuntes de 3º Higiene y Seguridad Alimentaria: higiene-y-seguridad-alimentaria.pdf
He publicado nuevos apuntes de 3º Tecnología Culinaria: Tecnologia-culinaria.pdf
He publicado nuevos apuntes de 2º Dietética y Farmacología Aplicada: apuntes-dietetica.pdf
He publicado nuevos apuntes de 2º Dietética y Farmacología Aplicada: dietetica-y-farmacologia-parte-2.pdf
He publicado nuevos apuntes de 2º Dietética y Farmacología Aplicada: FARMACOLOGIA.pdf
He publicado nuevos apuntes de 2º Microbiología y Parasitología: Microbiologia-parte-1.pdf